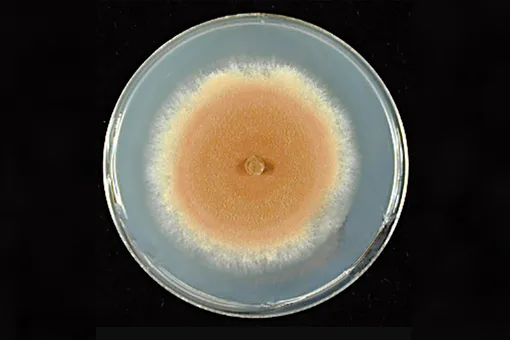

Сложная многоклеточная жизнь на Земле возникала независимо несколько раз: у животных, наземных растений, грибов, красных водорослей. Для большинства групп ископаемые останки служат надежным календарем эволюции. Красные водоросли появились около 1,6 миллиарда лет назад, животные — примерно 600 миллионов лет назад, наземные растения укоренились около 470 миллионов лет назад. Но грибы долгое время оставались загадкой: их мягкие тела плохо сохраняются в окаменелостях.
Грибы готовили Землю к жизни за сотни миллионов лет до появления растений
Чтобы устранить пробелы в летописи, ученые уже использовали молекулярные часы — метод датировки по накоплению генетических мутаций. Но команда OIST пошла дальше, применив новый подход: анализ горизонтального переноса генов между разными грибными линиями. «Если ген из линии А перескочил в линию Б, это устанавливает четкое правило: предки линии А должны быть старше потомков линии Б», — объясняет профессор Герджели Сёллёси, один из авторов работы. Статья опубликована в журнале Nature Ecology & Evolution.
Эпоха грибов

Идентифицировав 17 таких переносов генов, исследователи установили серию временных связей и уточнили грибную хронологию. Анализ показал, что общий предок современных грибов жил примерно 1,4–0,9 миллиарда лет назад — задолго до растений. Соавтор исследования доктор Ленард Сантхо подчеркивает: «Грибы управляют экосистемами — перерабатывают питательные вещества, кооперируются с другими организмами. Определение их временной шкалы показывает, что грибы развивались задолго до растений, взаимодействуя с водорослями и готовя почву для наземных экосистем».

Новая временная шкала переворачивает представление о колонизации суши. Сотни миллионов лет грибы разрушали породы, создавали примитивные почвы и изменяли континенты. Растения пришли не в безжизненную пустошь, а в мир, подготовленный древним грибным царством.